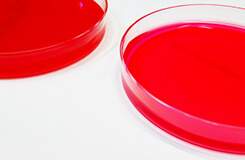
Hygiene Status Verification

Six Reasons to Choose WaterQualityAnalysis.comAbout us
Not all testing laboratories are the same. At WaterQualityAnalysis.com, we go beyond routine testing. Here is what sets us apart.
1. Dedicated Analyst Support from Start to Finish

Each project is assigned a dedicated analyst who oversees the entire process, providing tailored testing and accurate interpretation of results.
2. On-Site Water Sampling Service

Our trained staff provide on-site sampling in Tokyo, Kanagawa, Saitama, and Chiba, eliminating the burden of sample collection.
3. Rigorous Quality Control

We perform internal cross-checks and participate in external proficiency testing programs to ensure consistent accuracy and reliability.
4. Government-Registered Testing Laboratory

We are a registered laboratory for building drinking water quality testing and a certified Measurement Certification Agency (concentration). All reports and certificates issued by our laboratory are recognized as official documents.
5. More Than 14,000 Tests Conducted Annually

Trusted by clients across diverse industries for water quality, bacteriological, and environmental testing.
6. Nationwide Coverage with Express Service Available

We accept samples from across Japan and offer expedited testing when urgent results are required.
Confidence in the essentials of everyday life
Water Quality TestingExamination of water
-
Why Is Water Quality Testing Necessary?
An explanation of why testing is essential in different usage scenarios.
-
Water Quality Testing for Building & Residential Properties
Regular testing is indispensable where water is shared by many occupants.
-
Water Quality Testing for Public Facilities
Ensuring safe and reliable water for public use.
What cannot be seen can be measured.
Bacteriological TestingBacteria test
A safer environment through verified cleanliness.
Environmental Analysis / Other TestingEnvironmental analysis
From Request to
Test Completion
1
Place Your Order
2
Sampling Kit Delivery
3
Sample Collection
6
Report Delivery
5
Testing
4
Return Shipment
Case Studies
“Can we really drink this
well water in an emergency?”
Well Water Quality TestingIndividual Customer
A customer wanted to know whether their home well water could serve as drinking water if the municipal supply was disrupted by a disaster. Based on the intended use and surrounding environment, we conducted an 11-item water quality test. The results showed that certain parameters did not meet drinking water standards. Identifying this in advance allowed the customer to plan accordingly and prepare with confidence.
“Where is this
leaking water coming from?”
Leak Water Testing — Property ManagerCorporate Customer
A property manager reported a persistent water leak near a condominium entrance and needed to determine whether it was tap water, domestic wastewater, or rainwater. Since the leak occurred even in dry weather, we performed standard leak analysis along with supplementary tests for hardness and free residual chlorine — indicators characteristic of tap water. The results pointed to a tap water source, enabling the repair team to focus their investigation effectively.
About WaterQualityAnalysis.comCompany

To protect public health and the environment through accurate testing supported by expertise and experience.
Message
From the water you drink to the facilities you use, countless tests are performed every day to ensure
safety and reliability.
WaterQualityAnalysis.com addresses potential risks through professional testing services for both
individuals and organizations.
Your inquiry is handled directly by an experienced analyst who provides appropriate technical guidance
and solutions.